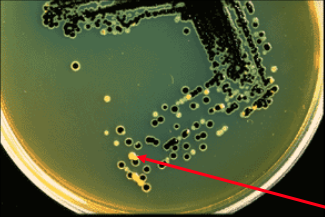

what is shigella’s biology?
Gram Negative Bacilli
Non-Motile
Non-lactose fermenter
No H2S production
Oxidase (-)**
how many strains does shigella have? what are they?
- S. dysenteriae
- S. Flexneri
- S. boydii
- S. sonnei
how does shigella spread?
Human Restricted* Fecal-oral
what is the most common strain in USA?
S. sonnei
what is the most deadly strain of shigella?
S. dysenteriae
how does shigella move from cell-to-cell? what does it use to do this?
it rockets from cell to cell using T3SS
what symptom is representative of a shigella infection?
fever
can shigella live intracellularly?
no
what cell will shigella infect?
M cells of colon via T3SS.
how does shigella acquire the shigella toxin?
through a bacteriophage
how does shiga toxin affect M cells?
cleaves 28S rRNA ceasing translation resulting in cellular apoptosis
why does shigella toxin cause hemorrhaging?
due to damage to blood vessels
what is shigellosis?
shigella dysentery
what are the symptoms of shigellosis?
- Very high fever (up to 106°F)
- Small volume bloody diarrhea containing WBC and mucus
- **Profuse blood-liquid diarrhea if Shigella toxin-strain
what complications can arise with shigellosis?
- Septic Arthritis
- Reactive Arthritis in HLA-B27 Patients
- HUS* –Hemolytic Uremic Syndrome
what agar can be used to grow shigella?
Hektoen (HE) Agar
what agar is this?
what are the white spots?
what are the black spots?
Hektoen (HE) Agar
shigella
salmonella
which is shigella?

left (stab) because shigella is non-motile
what treatment do you give to infection with s. sonnei?
supportive only
what treatment do you give to other shigella infection?
TMP-SMX or fluoroquinones when it has complicated


